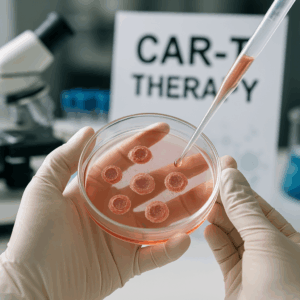

La terapia de células CAR-T, ¡vaya, qué avance! Es un cambio radical en el mundo de la oncología. Combina ingeniería genética e inmunoterapia para luchar contra enfermedades que causan cáncer, ¿sabes?
Este tratamiento, totalmente hecho a medida para cada persona, ha demostrado ser muy efectivo en cánceres que afectan la sangre. Pero eso no es todo, porque abre caminos fascinantes para atacar tumores sólidos. Y ahora, las investigaciones más recientes nos están mostrando que el alcance de este tratamiento podría ser aún mayor, ¡increíble!
Cómo funciona y su base biológica
En la terapia CAR-T, o «células T con Receptor Quimérico de Antígeno», los científicos modifican genéticamente las células T del cuerpo. Lo hacen para que estas células reconozcan y destruyan las células cancerosas. ¡Es como programar las defensas del cuerpo! Y el proceso es como sigue, en tres simples pasos:
1. Extracción con aféresis: Primero, se toman las células T directamente de la sangre del paciente.
2. Modificación genética: Luego, en el laboratorio, insertan un gen especial. Este gen crea un receptor quimérico (CAR). Este CAR está diseñado para reconocer y unirse a antígenos específicos que se encuentran en las células tumorales.
3. Reinfusión: Después, las células T modificadas, ya listas, se multiplican en grandes cantidades y se vuelven a inyectar en el paciente, con el objetivo claro de atacar y destruir el cáncer.
Y aquí va la magia de los receptores CAR: actúan como «llaves» que se unen a «cerraduras» (antígenos) en las células malignas. Esto es fundamental porque ayuda a superar la limitación que tienen los linfocitos naturales para detectar y atacar los tumores. ¡Impresionante!
¡Vale! Vamos a darle un poco más de chispa a eso, eh?
Cada diseño de CAR, ¿sabes?, está pensado específicamente para atacar ciertos antígenos, ¿comprendes? Por ejemplo, tenemos el CD19 en leucemias/linfomas B, después el BCMA en el mieloma múltiple, y también el GD2 en neuroblastoma… ¡si, eso!
## Usos prácticos, ahora mismo… ¡así son las cosas!
Este tipo de tratamiento… ya está aprobado para lo siguiente:
La leucemia linfoblástica aguda (LLA), ¡pero cuando es refractaria!, o sea, que no responde…
Linfomas difusos de células B grandes
¡Y el mieloma múltiple! …cuando reincide.
Los estudios, ¿sabes?, indican que las tasas de remisión completa andan por ahí, más o menos, del 50 al 70% en pacientes… bueno, que no tenían otras opciones, vaya[5][6]. En el Hospital Clínic de Barcelona, por ejemplo, se han aplicado terapias CAR-T académicas, como ARI-I y ARI-II y con muy buen resultado; ya se han tratado con éxito a más de 500 pacientes. Increíble, ¿verdad?
Ventajas cruciales frente a los tratamientos tradicionales:
| Rasgo clave | Terapia CAR-T | Quimioterapia/Radioterapia |
|——————-|——————————-|—————————————|
| Precisión | Ataca a antígenos tumorales | Impacta tanto células sanas como las cancerosas |
| Memoria inmunológica | Células permanecen por años | Efecto solo dura un tiempito |
| Adaptación personal | Usa células del mismo paciente | Usa protocolos que ya están hechos y aprobados |
Novedades en la investigación actual
Explorando nuevos horizontes para tumores sólidos
Inicialmente reservada a cánceres sanguíneos, la investigación de ahora mismo está explorando un montón de aplicaciones en:
– Glioblastoma: La cosa es que se administra directamente dentro del cerebro, a través de un catéter, y se ve respuesta en un 30% de los casos.
– Neuroblastoma: En un caso que se trató, hay una remisión que ya lleva más de 18 años![6]
– Cáncer de ovario/páncreas: Aquí, la idea es diseñar CAR-T para ir contra antígenos específicos como MUC1 o mesotelina.
Una terapia de doble diana (CAR-T biespecífica) ayuda a disminuir la resistencia del tumor al atacar a la vez dos antígenos diferentes. En modelos que se hacen antes de probarlo en humanos, esta estrategia aumenta la efectividad del 40% al 75%
### Mejoras en Seguridad y Eficacia… ¿Qué Sigue?
Bueno, las CAR-T de nueva generación están incluyendo un par de cosillas interesantes:
Sistemas de seguridad integrados: Poniendo genes tipo «apagado» para ayudar a controlar esos efectos adversos que dan guerra
Blindaje para CAR-T: Modificaciones que las hacen más resistentes al entorno hostil del tumor, para que no se achicharen en el microambiente tumoral[6]
CAR-T listas para usar: Estamos hablando de CAR-T alogénicas, hechas como en serie, usando donantes sanos. Que bueno, simplifica mucho las cosas[7]
Un estudio de 2025 en la revista _Nature Medicine_ nos mostró algo clave: ¡La carga tumoral inicial es determinante! La supervivencia a 5 años es abismalmente diferente, 85% si hay poca carga vs. solo un 20% si la enfermedad está avanzada . Vaya, eso es importante.
Desafíos y Lo Que Viene
Claro que, no todo es color de rosas, eh? Todavía hay limitaciones:
Efectos secundarios potentes: El síndrome de liberación de citoquinas da lata en un 40% de los casos y la neurotoxicidad, no nos deja respirar en un 15-25%[1][5]
Un pastón de tratamiento: Ufff… El precio, unos 300,000 USD por tratamiento.
Logística pesada: Necesitamos centros superespecializados. Eso es un problema.
Pero la investigación está enfocada en un par de cosas:
1. Biomarcadores: Identificando a los pacientes que puedan beneficiarse más, vamos, aquellos con altas posibilidades de que funcione el tratamiento
2. Combinaciones: Investigando la unión de CAR-T con inhibidores del punto de control inmunitario, una opción promisoria.
3. Aplicaciones no oncológicas: No solo en cáncer, sino pensando en diabetes tipo 1, enfermedades autoinmunes e incluso el VIH. Ya, que va a ver con qué van a salir.
Y, bueno, Carl H. June, el que le puso el cascabel al gato con esta técnica, predice que para 2030, ¡el 50% de los cánceres podrían tratarse con estas inmunoterapias genéticas![4] Mientras tanto, equipos como el del Clínic-IDIBAPS están trabajando en protocolos para administrar CAR-T como segunda línea terapéutica, prometiendo mejores resultados que la quimioterapia estándar (70% vs 50% de remisiones). Así que la lucha sigue..
El panorama en este campo, definitivamente, está cambiando… evolucionando hacia terapias que son más accesibles, y por supuesto, muy versátiles, ¿no? Resulta que para el año 2025, ¡se estiman 1,200 ensayos clínicos activos! . Los progresos en la edición genética, ¡qué cosa! como la técnica CRISPR/Cas9, junto a los modelos predictivos _in silico_ prometen una gran aceleración en el desarrollo de los CAR-T de cuarta generación; eso sí, la idea es posicionarlos como una herramienta CLAVE, importantísima, en la medicina personalizada contra el cáncer.
Vale, aquí vamos, adaptando esas URLs para una vibra más humana y con algo más de rollo, sin cambiar lo que intentan decir, ¿eh?
Primero, échale un ojo a esta página web… ¡es sobre comprender la terapia con células CAR-T para el cáncer! Un experto de Mayo Clinic te lo explica todo, cómo funciona y demás, un montón de detalles interesantes. La URL es bastante larga, mira: orges20240903comprender-la-terapia-con-celulas-car-t-para-el-cancer-experto-de-mayo-clinic-explica-como-funciona.
ACERCA DEL CORRESPONSAL
FRANCISCO JAVIER MARíN MAURI
Me lincencié en psicología por la Universidad de Sevilla. estudios de virología por la Universidad jhons Hopkins y estudios de virus respiratorios emergentes por la O.M.S. Doctorado en neuropsicología por la Universidad de Sevilla. Especialista en Violencia sobre la mujer y en mediación de conflictos sociales.
Llevo desde 1987 ejerciendo la psicología y cada vez pienso más que muchas personas se van de este mundo sin quitarla el sello de fábrica de sus cerebros. Anduve durante casi dos años por varios países africanos para poder realizar mi tesis doctoral sobre el VIH. Ahí aprendes que el poder de la ciencia consiste en tener la suficiente humildad para ejercitar el sentido común que es, por cierto, el menos común de los sentidos.

